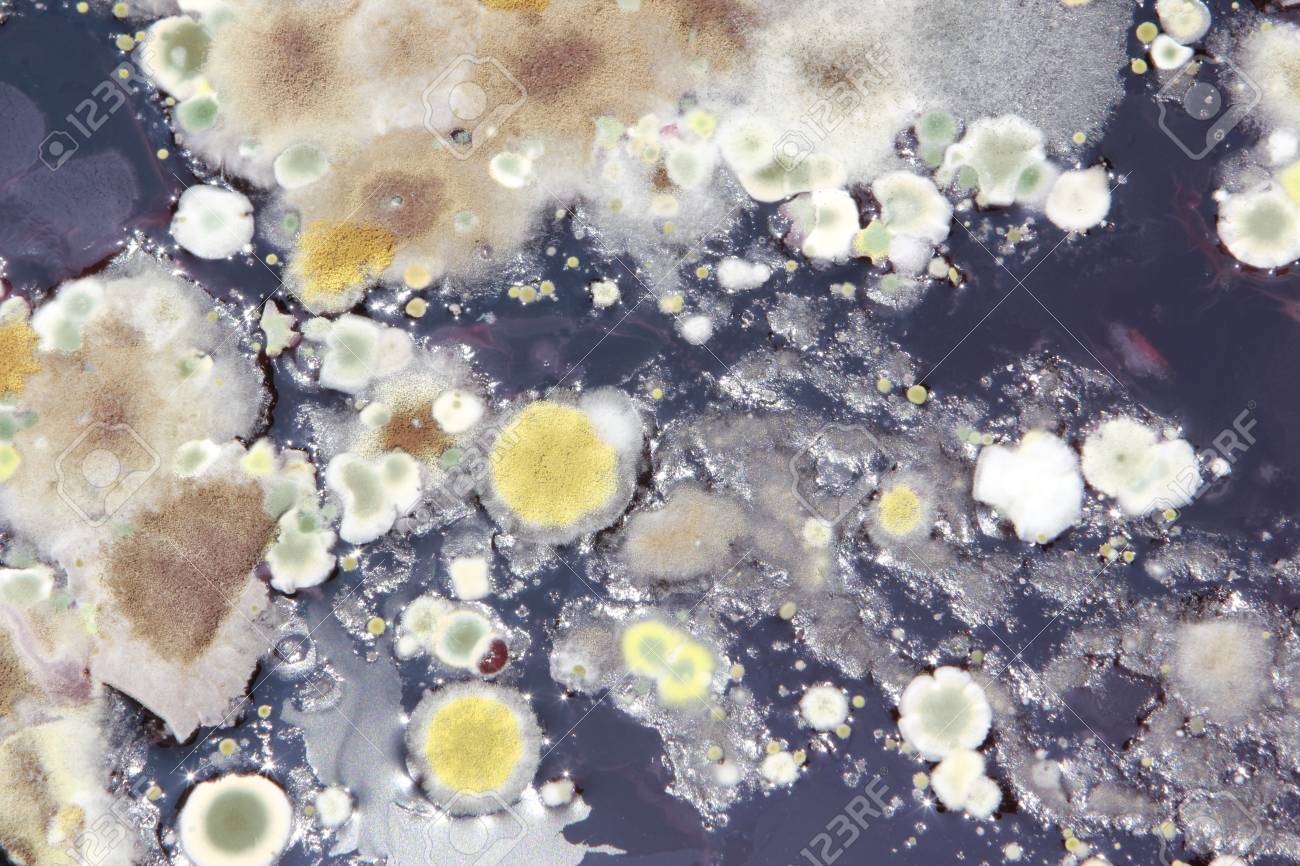
etiam-dictum-ipsum-a-felis

Download
Close
Автор:
id:
Ключевые слова:
agar, background, bacteria, bacterium, biological, biology, biotechnology, cells, circular, closeup, colony, culture, decayed, ecosystem, filamentous, fungi, fungus, fuzzy, germs, green, growing, lab, life, messy, micro, microbes, microbial, microbiology, microorganism, mold, moldy, mould, mouldy, nobody, organism, putrid, rancid, research, rnabstract, rnagar agar, rninfection, rnlaboratory, rnmildew, rnpenicillium, rnround, rnstinking, rotten, science, scientific, spoiled, spores, study, substance, sullen, technology, tiny, wry,





